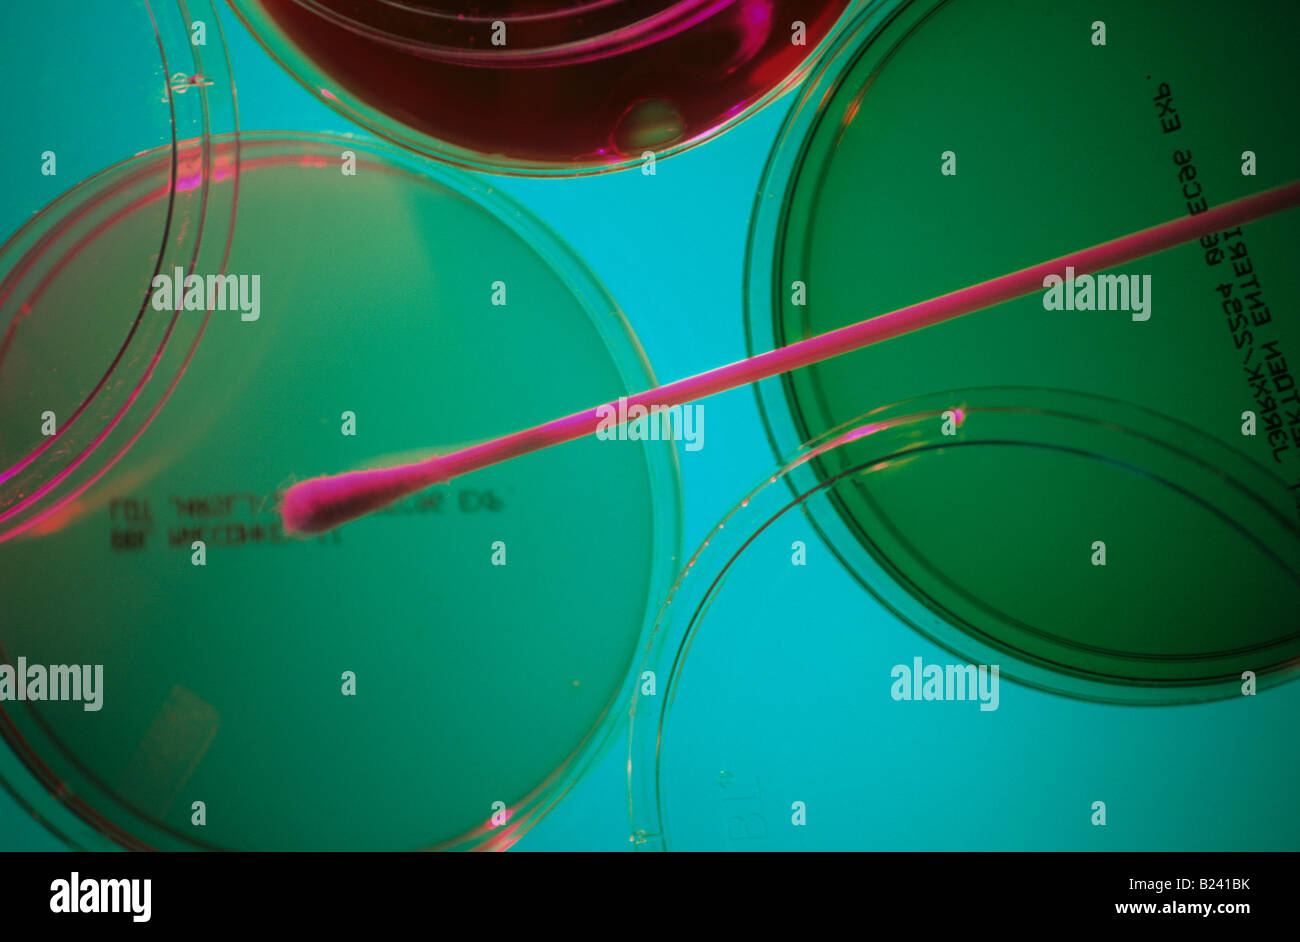

Agar Petri dishes and blood agar culture media are essential laboratory tools used for scientific research and experimentation. In this post, we will share the recipe and instructions for making agar Petri dishes and blood agar culture media.
Agar Petri dishes
To make agar Petri dishes, you will need:
- Agar (10g)
- Beef extract (5g)
- Peptone (10g)
- Distilled water (1L)
- Autoclave
- Petri dishes
Follow these instructions:
- Mix the agar, beef extract, and peptone in a flask with distilled water.
- Stir the mixture until it dissolves.
- Autoclave the mixture at 121°C for 15 minutes.
- Pour the mixture into sterile Petri dishes.
- Let the mixture cool and solidify.
- Store the Petri dishes in a cool, dry place until use.
Agar Petri dishes are used to grow a variety of microorganisms, such as bacteria and fungi, for research and experimentation.
Blood agar culture media
To make blood agar culture media, you will need:
- Agar (10g)
- Beef extract (5g)
- Peptone (10g)
- Sheep blood (50ml)
- Distilled water (1L)
- Autoclave
- Petri dishes
Follow these instructions:
- Mix the agar, beef extract, and peptone in a flask with distilled water.
- Stir the mixture until it dissolves.
- Autoclave the mixture at 121°C for 15 minutes.
- Cool the mixture to approximately 50°C.
- Mix in sheep blood.
- Pour the mixture into sterile Petri dishes.
- Let the mixture cool and solidify.
- Store the Petri dishes in a cool, dry place until use.
Blood agar culture media are used to grow microorganisms, such as Streptococcus and Staphylococcus, for research and experimentation. The addition of sheep blood to the agar provides nutrients and a source of hemoglobin for the microorganisms to grow.
Conclusion
Agar Petri dishes and blood agar culture media are crucial tools in scientific research and experimentation. By following these simple recipes and instructions, you can create high-quality laboratory tools for growing and studying microorganisms for research and experimentation.


If you are looking for PETRI DISH WITH BLOOD AGAR CULTURE MEDIA Stock Photo: 18528599 - Alamy you've came to the right place. We have 35 Pictures about PETRI DISH WITH BLOOD AGAR CULTURE MEDIA Stock Photo: 18528599 - Alamy like How to Sterilize Petri Dishes | Sciencing, Nutrient Agar in Petri Dishes. Stock Photo - Image of experiment and also Compare Price: pre poured agar petri dishes - on StatementsLtd.com. Read more:
PETRI DISH WITH BLOOD AGAR CULTURE MEDIA Stock Photo: 18528599 - Alamy
 www.alamy.com
www.alamy.com Malt Extract Agar In Petri Dishes | Biology Supplies - Darwin Biological
 www.darwinbiological.co.uk
www.darwinbiological.co.uk agar malt petri
Malt Extract Agar Petri Dishes | 1st For Quality | Viking Spores
 vikingspore.co.uk
vikingspore.co.uk Petri Dishes With Agar
 www.teachers-tools.com
www.teachers-tools.com petri agar dishes learning resources
Malt Extract Agar Media In Petri Dishes, 9,90 €, Medicinal Mushroom
 gluckspilze.com
gluckspilze.com Petri Dish With Agar Kit
 www.adventuretowntoys.com
www.adventuretowntoys.com petri
How To Make Agar Gel From Powder | Petri Dish, Petri Dishes, How To Dry
 www.pinterest.com
www.pinterest.com agar gel powder ehow getty petri
Petri Dish With Bacterial Colonies On Agar-agar Stock Image - Image Of
 www.dreamstime.com
www.dreamstime.com petri colonies bacterial aga kolonien petrischale bakteriellen colonias bacterianas femeninas llevan cabo halten weibliche hände microbios sosteniendo
Malt Extract Agar In Petri Dishes | Biology Supplies - Darwin Biological
 www.darwinbiological.co.uk
www.darwinbiological.co.uk malt petri agar extract dishes em
Nutrient Agar In Petri Dishes. Stock Photo - Image Of Experiment
 www.dreamstime.com
www.dreamstime.com petri nutrient nutriente preparation
Nutrient Agar In Petri Dishes. Stock Image - Image Of Laminar
 www.dreamstime.com
www.dreamstime.com agar petri nutrient
Petri Dishes 1 Is A New Twist On My Microbiology Theme. Brightly
 www.pinterest.com.au
www.pinterest.com.au petri dishes dish watercolor microbiology bacteria microorganisms collage paper projects brightly colored theme painting original paintings handmade banks science etsy
Nutrient Agar In Petri Dishes | Biology Supplies - Darwin Biological
 www.darwinbiological.co.uk
www.darwinbiological.co.uk agar petri nutrient dishes em
Agar Medium In Petri Dish For Microbial Plate Count Stock Image - Image
 www.dreamstime.com
www.dreamstime.com petri dish microbial
Nutrient Agar Plate At Rs 30/piece | अगर प्लेट - JC Diagnostics
 www.indiamart.com
www.indiamart.com Making Agar Petri Dishes
petri
Petri Dishes & Agar: Science Lab Petri Dishes: Amazon.com: Industrial
 www.amazon.com
www.amazon.com sorry petri
20 Custom Color Pre-poured Agar Petri Dishes Polystyrene 100mm | Etsy
 www.etsy.com
www.etsy.com agar poured petri 100mm polystyrene
PETRI DISH WITH BLOOD AGAR CULTURE MEDIA Stock Photo - Alamy
www.alamy.com
www.alamy.com petri agar dish blood alamy culture
Petri Dishes With Blood Agar And Bacterial Colonies Stock Image - Image
 www.dreamstime.com
www.dreamstime.com petri agar colonies blood bacterial dishes culture aur staphylococcus growth laboratory preview growing
Contam On Petri Dish? - Mushroom Cultivation - Shroomery Message Board
 www.shroomery.org
www.shroomery.org petri cobweb dish mold agar shroomery contam growth identify mushroom
Compare Price: Pre Poured Agar Petri Dishes - On StatementsLtd.com
 statementsltd.com
statementsltd.com petri poured dextrose fungus pda molds
I Swabbed My Makeup Brush And A Cell Phone Onto A Petri Dish With Agar
 www.reddit.com
www.reddit.com cell makeup petri agar dish phone swabbed brush onto results were these comments imgur
First Time With Agar / Petri Dishes - How Does The Growth Look So Far
shroomery agar petri dishes look growth far does so
Bacterial Culture Growing In A Petri Dish On Agar Jelly Stock Photo - Alamy
 www.alamy.com
www.alamy.com agar jelly petri dish bacterial growing alamy culture
Petri Dishes & Agar Set Of 3 (Aep7Ch001Crt) - Lab Equipment For The
 www.teachchildren.com
www.teachchildren.com petri agar dishes
Agar Plates Petri Dishes
petri dishes plastic 15mm agar plates 100mm 60mm 35mm sleeve 150mm common analyticalsci p242 p240
Petri Dishes And Agar Oh My! | For Growing Bacteria Of Cours… | Flickr
 www.flickr.com
www.flickr.com goodncrazy bacteria
20 Custom Color Pre-poured Agar Petri Dishes Polystyrene 100mm | Etsy
 www.etsy.com
www.etsy.com agar petri poured 100mm polystyrene
1000+ Images About Don't Take It Home With You. On Pinterest | Giardia
 www.pinterest.com
www.pinterest.com jello science petri shots food dish shooters recipe microbiology choose board dishes recipes
How To Make Agar Petri Dishes - YouTube
 www.youtube.com
www.youtube.com petri dishes agar
Stacks Of Petri Dishes In A Laboratory — Workplace, Science - Stock
 focusedcollection.com
focusedcollection.com stacks petri science
Luria Broth Agar, Prepoured Plates | Carolina.com
 www.carolina.com
www.carolina.com agar plates broth luria plate puromycin carolina lb selection culture
Pre-Poured Agar Dishes & Slants
 mushvroom.com
mushvroom.com poured petri slants
How To Sterilize Petri Dishes | Sciencing
petri nutrient
Petri nutrient nutriente preparation. 20 custom color pre-poured agar petri dishes polystyrene 100mm. Agar jelly petri dish bacterial growing alamy culture
